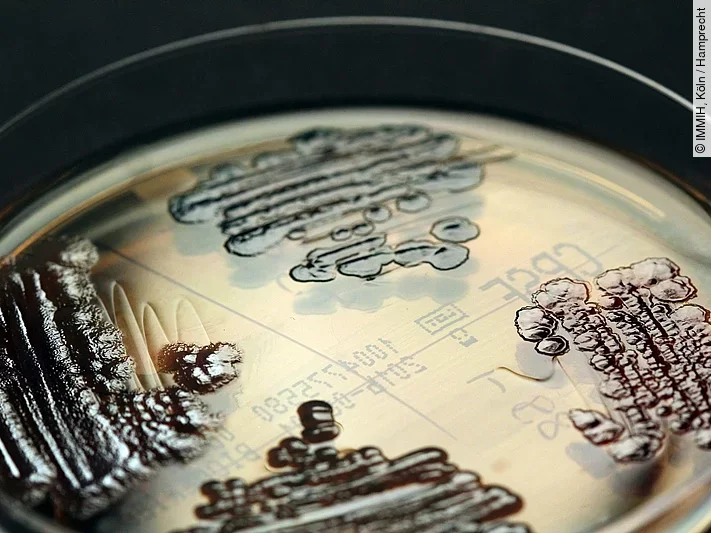
Multiresistente Keime Multiresistente Keime

Nach dem Nachweis multiresistenter Erreger in vier Kliniken hat das Landesamt für Gesundheit und Soziales (Lagus) alle Krankenhäuser im Land zu einer Ausweitung der Screening-Maßnahmen aufgefordert. Untersucht werden sollen alle Patienten, die in den vergangenen sechs Monaten stationär in einem der betroffenen Krankenhäuser im Landkreis Vorpommern-Greifswald behandelt wurden, teilte das Landesamt am Mittwoch mit.
Alle Krankenhäuser sollten zudem Kontakt mit den für sie tätigen Laboren aufnehmen. Diese sollten alle Proben von multiresistenten Stämmen des Typs 4MRGN zur weiteren Untersuchung an das Nationale Referenzzentrum in Bochum schicken. Die Reha-Kliniken im Land wurden gebeten, ebenfalls ihr Screening auszuweiten, sofern Patienten aus einem der vier betroffenen Krankenhäuser bei ihnen behandelt werden, die kein Entlassungsscreening erhielten. Eine entsprechende Information gehe auch an alle Gesundheitsämter der Landkreise und kreisfreien Städte, sagte eine Sprecherin. Es sei wichtig, eine lückenlose Informationskette aufzubauen und die Verbreitungswege des Keims zu erforschen.
Die Linksfraktion im Landtag forderte den Aufbau eines systematischen Eingangs- und Entlass-Screenings für alle Patienten an den Krankenhäusern. Derzeit gibt es laut Lagus solche Screenings nur für Risikopatienten, wie Bewohner von Pflegeheimen oder bestimmte Auslandsreisende.
Erreger ist behandelbar
Der gesundheitspolitische Sprecher der Linken, Torsten Koplin, forderte zudem, die Forschung auf diesem Gebiet zu verstärken. „Hier sehen wir insbesondere das Robert-Koch-Institut und unsere beiden Universitätsmedizinen in der Pflicht.” Auch erwarte die Fraktion, dass in allen Regionen Netzwerke zur Prävention und Kontrolle von resistenten Infektionserregern gebildet werden.
Am Dienstag hatten das Lagus und die Universitätsmedizin Greifswald mitgeteilt, dass bei 14 Patienten eine spezielle Form des Darmbakteriums Klebsiella pneumoniae nachgewiesen wurde. Dieser Untertyp des Erregers habe einen besonderen Mechanismus entwickelt, zwei Enzyme zu bilden, die die üblichen Antibiotika aufspalten und unwirksam machen, sagte der Chefhygieniker der Universitätsmedizin Greifswald, Nils Hübner. Der Erreger sei trotzdem behandelbar, drei Reserve-Antibiotika stünden zur Verfügung.
Von den 14 Patienten sind laut Lagus sechs an einer Infektion durch den Erreger erkrankt. Bei acht Patienten wurde er nachgewiesen, ohne dass sie an ihm erkrankten. Für gesunde Menschen ist der multiresistente Erreger Hübner zufolge nicht gefährlicher als die nicht resistente Variante.





Derzeit sind noch keine Kommentare vorhanden. Schreiben Sie den ersten Kommentar!
Jetzt einloggen